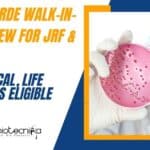
DRDO-DRDE Walk-In-Interview For JRF & RA – Biological, Life Sciences Eligible DRDO-DRDE Jobs 2022

Home Search
biology - search results
If you're not happy with the results, please do another search
DRDO-DRDE Walk-In-Interview For JRF & RA – Biological, Life Sciences Eligible
DRDO-DRDE Jobs 2022 For JRF & RA - Biological, Life Sciences Eligible
DRDO-DRDE Jobs 2022 For JRF & RA - Biological, Life Sciences Eligible. DRDO...
Biotecnika Times Newsletter 03.10.2022 Over 250+ Freshers Jobs, FAST 2023, Govt HSSC Jobs
Biotecnika Times Newsletter 03.10.2022 Over 250+ Freshers Jobs
C-DAC 250+ Freshers Jobs & 200+ Experience Based Vacancies For Biotech, Bioinformatics – Apply Online
C-DAC Pune Jobs...
PhD Biological Sciences, Biophysics, Comp Bio Research Associate Recruitment at IISER Pune
PhD Biological Sciences, Biophysics, Comp Bio Research Associate Recruitment
PhD Biological Sciences, Biophysics, Comp Bio Research Associate Recruitment. RA Vacancy for PhD candidates. Interested and...
ICAR-IARI Agricultural Sciences, Biotech YP Job Opening, Attend Walk-In
ICAR-IARI Agricultural Sciences, Biotech YP Job Opening, Attend Walk-In
ICAR-IARI Agricultural Sciences, Biotech YP Job Opening, Attend Walk-In. ICAR-IARI job openings. MSc Biotechnology/Plant Breeding and...
NIRRCH JRF Opportunity For MSc Life Sciences, Apply Online
NIRRCH JRF Opportunity For MSc Life Sciences, Apply Online
NIRRCH JRF Opportunity For MSc Life Sciences, Apply Online. NIRRH recruitment for JRF vacancy. NIRRCH National...
YRG Care Chennai Hiring Bioinformatics Candidates For JRF Vacancy
YRG Care Chennai Hiring Bioinformatics Candidates For JRF Vacancy
Advertisement for the post of junior research fellow
Applications are invited for a temporary position of Junior...
HaystackAnalytics Hiring For Technical Associate Vacancy, Applications Invited
HaystackAnalytics Hiring For Technical Associate Vacancy, Applications Invited
HaystackAnalytics is looking for an enthusiastic individual who is proactive and highly motivated, willing to roll up...
HaystackAnalytics Technical Officer Job Opportunity, Applications Invited
HaystackAnalytics Technical Officer Job Opportunity, Applications Invited
HaystackAnalytics is looking for an enthusiastic individual who is proactive and highly motivated, willing to roll up their...
1-2 Year Internship In Vaccine Prodn & Allied Areas at Pasteur Institute of India
Microbiology Internships India 2022 - Applications Invited
Microbiology Internships India 2022 - Applications Invited. Pasteur Institute of India Internships. BTech Biotech Internship 2022. MSc Microbiology...
RGCB BSc & PhD Life Sciences, Biotechnology Research Job, Apply Online
RGCB BSc Jobs, PhD Biotech, Life Sciences - Apply Online
RGCB BSc Jobs, PhD Biotech, Life Sciences - Apply Online. Rajiv Gandhi Centre for Life...
Biotecnika Times Newsletter 30.09.2022 Govt HPSSC Jobs, CSIR-IGIB, NIFTEM, Reliance Hiring
Biotecnika Times Newsletter 30.09.2022 Govt HPSSC Jobs, CSIR-IGIB, NIFTEM, Reliance Hiring
Govt HPSSC Food Safety Officer Recruitment – Online Application Portal OPEN
Govt HPSSC Food Safety...
NIANP Biotech, Biochem, Mol Bio, Genetics Jobs, Applications Invited
NIANP Biotech, Biochem, Mol Bio, Genetics Jobs, Applications Invited
NIANP Biotech, Biochem, Mol Bio, Genetics Jobs, Applications Invited. Bengaluru jobs. NIANP Bengaluru vacancies. MSc SRF/RA...
NIRRCH Biological Sciences Project Assistant Recruitment, Apply Online
NIRRCH Biological Sciences Project Assistant Recruitment, Apply Online
NIRRCH Biological Sciences Project Assistant Recruitment, Apply Online. NIRRH recruitment for Project Assistant vacancy. NIRRCH National Institute...
THSTI MSc Life Sciences Technical Officer Jobs, Applications Invited
THSTI Vacancies 2022 For Life Sciences, Applications Invited
THSTI Vacancies 2022 For Life Sciences, Applications Invited. MSc Life Sciences jobs. Interested and eligible applicants can...
Reliance Industries Research Scientist For MSc & PhD Biotech, Biochem, Biophysics
Reliance Industries Research Scientist For MSc & PhD Biotech, Biochem, Biophysics
Reliance Industries Research Scientist For MSc & PhD Biotech, Biochem, Biophysics. Interested and eligible...